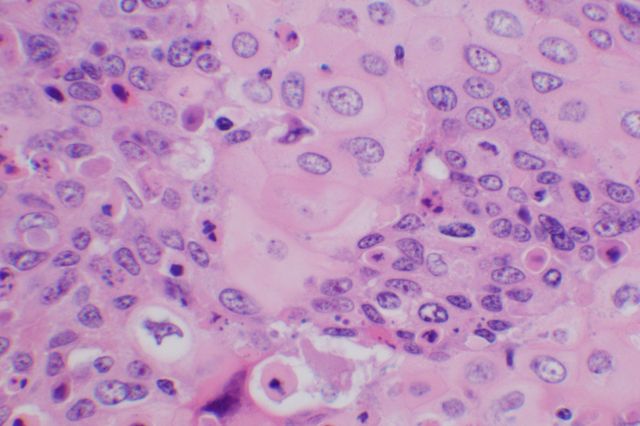
Cervical cancer cells

UCLA scientists have identified a protein that has the potential to prevent the growth of cervical cancer cells. The discovery could lead to the development of new treatments for the deadly disease.
In a five-year study using human samples and mouse models, researchers led by Dr. Eri Srivatsan, a member of the UCLA Jonsson Comprehensive Cancer Center, found that a protein known as cystatin E/M can inhibit cellular inflammation, which is a major contributor to the growth of cervical cancer.
Typically, inflammation develops after a woman contracts the human papilloma virus from a male partner; the virus can eventually lead to the development of cervical cancer. Environmental factors such as smoking also are closely associated with the disease.
The UCLA researchers discovered that cystatin E/M prevents a protein called NFkB, which regulates inflammation, from entering the nucleus of cervical cancer cells. As a result, decreased inflammation slows tumor cell growth.
“When key inhibitory mechanisms break down, cancer cells produce inflammation that helps fuel cancer cell growth,” said Srivatsan, who is a professor in UCLA’s department of surgery. “By identifying this protein, we have discovered a key regulator of this breakdown. This is the first time we have found that inhibition of the protein kinase by cystatin E/M plays a regulatory role in cell inflammation.”
The study is published online in the journal Molecular and Cellular Biology.
Worldwide, cervical cancer is the second most common cause of cancer-related deaths in women. In the United States, HPV is detected in 90 percent of cervical cancer tumors and is the most common sexually transmitted disease, Srivatsan said.
Although cystatin E/M and its basic function had previously been identified, little else was known about the protein’s molecular activity until 2008, when Srivatsan and colleagues’ initial findings were published in Genes Chromosomes and Cancer.
The new study built upon that research. Srivatsan’s team analyzed 20,000 genes in two sets of cell lines — one set that expressed the cystatin E/M protein and the other that didn’t. They also analyzed 66 samples of normal and cancerous cervical tissues to determine the molecular mechanism that inhibits cancer cell growth.
In future research, Srivatsan’s team will aim to determine whether cystatin E/M could inhibit tumor cell growth in chemo-radiation–resistant breast cancers in human tissue culture and animal models.
Dr. Neda Moatamed, a UCLA assistant professor of pathology and laboratory medicine and a member of the Jonsson Cancer Center, was a co-author of the study. The research was supported by the VA Greater Los Angeles Healthcare System.